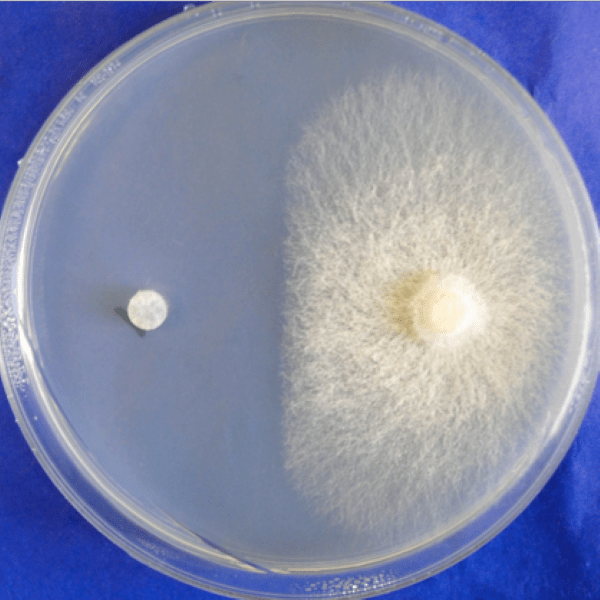

General Services Catalogue
Through this catalogue, explore a simple, direct catalogue of services provided by MIRRI-ERIC’s partner organisations. From supply, deposit or identification of microbial resources by gene sequencing, as well as advanced services, to genomics, screening of metabolites or phylogenetic analysis, find up to 95 services listed one-by-one.
For workflows/pipelines of services organised by purposes, please consult the MIRRI-ERIC’s Application-specific Service Catalogue.
*All images used are for illustrative purposes only
- Description
- General information
- Contact MIRRI
Test the resistance of a particular strain to different antibiotics
Screening, tests and bioassays
Growth promoting / antimicrobial / antiviral bioassays
Test the effect of different types of agents (e.g. compounds, extracts, soil, etc.) on the growth, replication or yield of a particular microbial strain, virus or plant